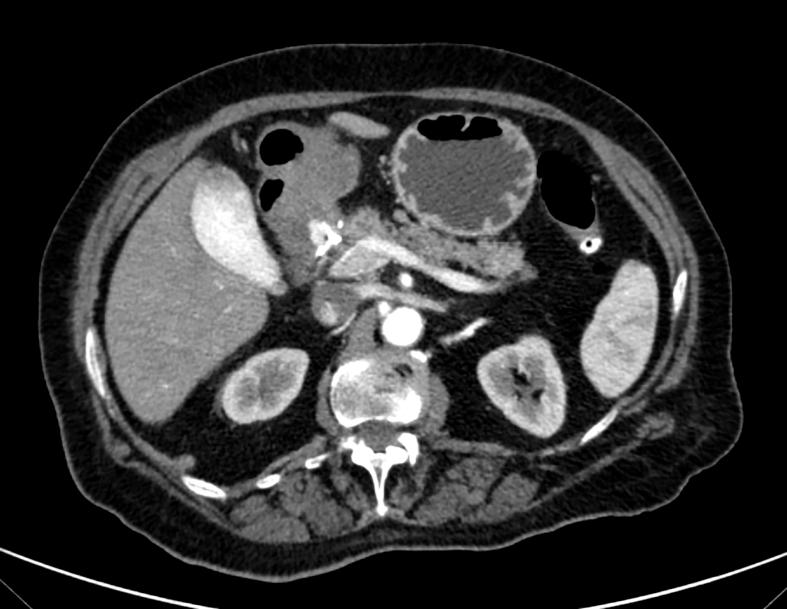
https://cdn.ncbi.nlm.nih.gov/pmc/blobs/953f/10800679/32ffe1b37bcd/gr4.jpg

巨大出血性胃十二指肠动脉动脉瘤:具有挑战性的诊断与治疗。病例报告。
Large and bleeding gastroduodenal artery aneurysm: Challenging diagnosis and treatment. A case report.
作者信息
Yusef Marco, Barone Sara Claudia, D'Angelo Francesco, Aurello Paolo, Silecchia Gianfranco, Petrucciani Niccolò
机构信息
Department of Medical and Surgical Sciences and Translational Medicine, Faculty of Medicine and Psychology, St Andrea Hospital, Sapienza University, Rome, Italy.
Department of Medical and Surgical Sciences and Translational Medicine, Faculty of Medicine and Psychology, St Andrea Hospital, Sapienza University, Rome, Italy.
出版信息
Int J Surg Case Rep. 2024 Jan;114:109105. doi: 10.1016/j.ijscr.2023.109105. Epub 2023 Dec 8.
INTRODUCTION
Visceral artery aneurysms (VAA), including gastroduodenal artery aneurysms (GAA), are rare pathologies that can be challenging to diagnose due to their often-asymptomatic nature. VAA are usually correlated to atherosclerosis, fibro dysplasia, or hemodynamics changes, while pseudo aneurysms are mostly correlated to infection, inflammation, traumas, or iatrogenic lesions.
PRESENTATION OF CASE
We report the case of an 82-years-old female presenting with abdominal pain and hematemesis. Upper gastrointestinal endoscopy retrieved a large duodenal mass and subsequent CT scans identified a large GAA with contrast extravasation. Endovascular procedure included selective arteriography, microcatheterization, and embolization.
DISCUSSION
VAA are mostly located in the splenic and hepatic artery. Symptoms of VAA are related to pressure on neighboring organs. VAA rupture is associated with a high mortality risk (over 76 %) and presents with symptoms like acute abdominal pain, hematemesis, and hemodynamic shock. Diagnosis is often made through CT scans and angiography. Treatment options for VAAs and GAAs include both surgical and endovascular methods. Endovascular treatment is preferred, with a success rate of 89 %-98 %.
CONCLUSION
This case provides an example of challenging diagnosis and treatment of a large and bleeding GAA.
引言
内脏动脉瘤(VAA),包括胃十二指肠动脉瘤(GAA),是罕见的病变,因其通常无症状的性质,诊断可能具有挑战性。VAA通常与动脉粥样硬化、纤维发育异常或血流动力学改变相关,而假性动脉瘤大多与感染、炎症、创伤或医源性病变相关。
病例介绍
我们报告了一例82岁女性,表现为腹痛和呕血。上消化道内镜检查发现十二指肠有一个大肿块,随后的CT扫描确定为一个大的GAA并伴有造影剂外渗。血管内治疗包括选择性动脉造影、微导管插入和栓塞。
讨论
VAA大多位于脾动脉和肝动脉。VAA的症状与对邻近器官的压迫有关。VAA破裂与高死亡风险(超过76%)相关,表现为急性腹痛、呕血和血流动力学休克等症状。诊断通常通过CT扫描和血管造影进行。VAA和GAA的治疗选择包括手术和血管内方法。血管内治疗是首选,成功率为89% - 98%。
结论
本病例提供了一个对大的、出血性GAA进行具有挑战性的诊断和治疗的例子。